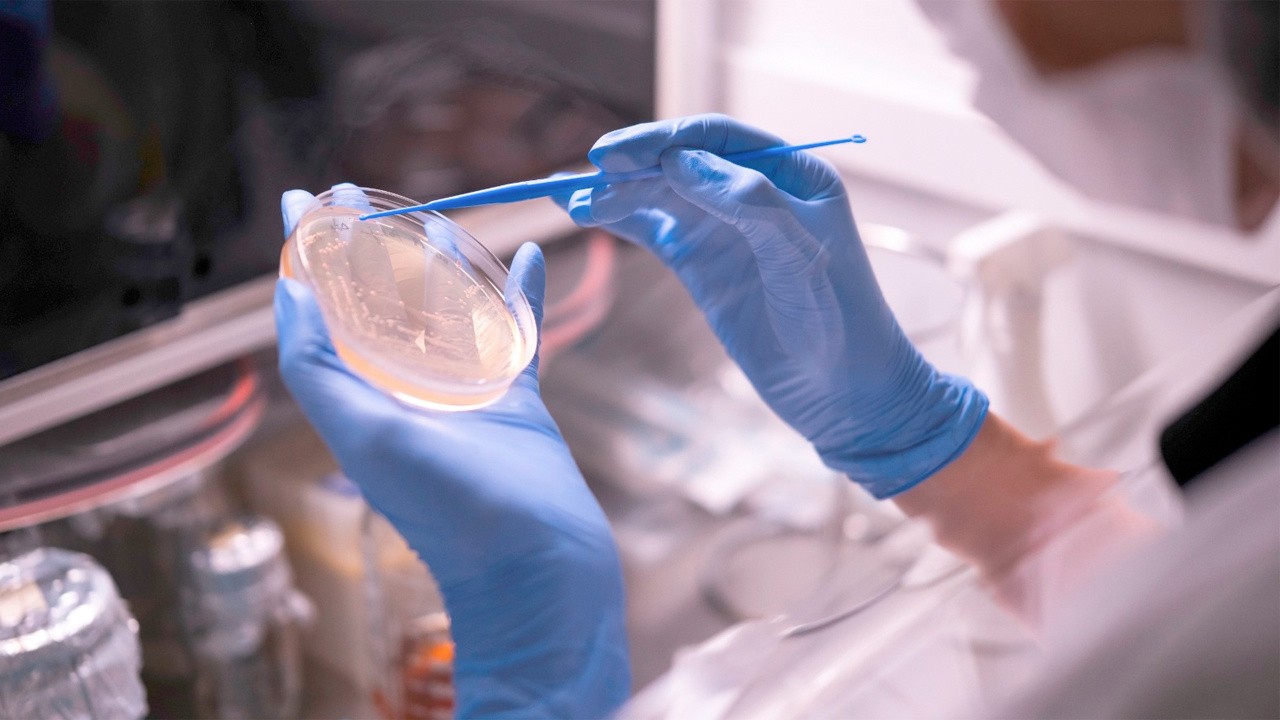

Orzaks’ın üretim gücü Nuvita İlaç, Ar-Ge yatırımıyla Türkiye’nin ilk 250 firması arasında
Orzaks’ın üretim faaliyetlerini üstlenen stratejik üretim merkezi Nuvita İlaç, Türkiye’nin en fazla Ar-Ge yatırımı yapan 250 firması arasına girdi.

Orzaks’ın üretim faaliyetlerini üstlenen stratejik üretim merkezi Nuvita İlaç, Türkiye’nin en fazla Ar-Ge yatırımı yapan 250 firması arasına girdi.
Tepkiniz nedir?






